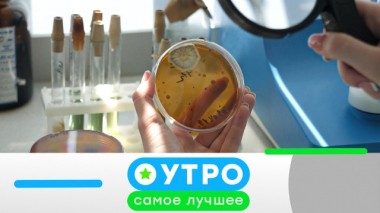
18 мая 2020 года 18.05.2020

НТВ / Утро. Самое лучшее / Выпуски / 30 мая 2023 года / 18.03.2019
Старинный рецепт шашлыка по-адыгейски. Автопутешествие в Дагестан. Один оформил договор, другой резко вышел, а третий остался должен: Верховный суд принял неожиданное решение по ОСАГО. Страховщики ответят и за пассажира даже патрульной машины. Все о капсульном кофе: влияет ли цена на вкус, может ли алюминий из покрышек попадать в напиток и есть ли в порошке кофеин? Какая административная ответственность предусмотрена за оскорбление личности. Проверка дачных гаджетов: настолько ли они полезны и способны упростить жизнь при работе на огороде. Боррелиоз: причины возникновения заболевания и методы его лечения.